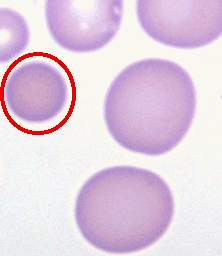
自身免疫溶血性貧血
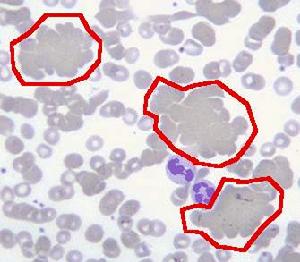
自身免疫溶血性貧血

概述
 自身免疫性溶血性貧血
自身免疫性溶血性貧血自身免疫性溶血性貧血(Autoimmunehemolyticanemia,AIHA),是一種獲得性溶血性疾患,由於免疫功能紊亂產生抗自身紅細胞抗體,與紅細胞表面抗原結合,或激活補體使紅細胞加速破壞而致溶血性貧血。
國外報導本病約占溶血性疾病患者總數的1/3。中國AIHA的發病率僅次於陣發性睡眠性血紅蛋白尿症,占獲得性溶血性貧血疾患的第二位,女性患者多於男性,以青壯年為多,其中溫反應性抗體型約占80%。
分類
按病因分類
臨床上根據發病原因把自身免疫性溶血性貧血分為:
1、原發性自身免疫性溶血性貧血原因不明確,占60%左右;
2、繼發性自身免疫性溶血性貧血:伴發於淋巴系統惡性腫瘤及與免疫有關的疾病,如淋巴瘤、慢性淋巴細胞性白血病、多發性骨髓瘤等及系統性紅斑狼瘡、類風濕性關節炎、某些細菌病毒感染等,約占40%左右。
按抗體不同分類
 自身免疫溶血性貧血
自身免疫溶血性貧血2、冷抗體,又分為兩種:
(1)、冷凝素與紅細胞結合的最適宜溫度是2~4℃,溫度上升結合力減弱;
(2)、冷溶血素在16℃時與紅細胞結合,溫度升高結合力無明顯減弱。
臨床上溫反應性抗體型約占80%,女性患者多於男性,且以青壯年為多。
病因
原發AIHA
無明確病因的AIHA為原發性AIHA。中國報導占39.7%~58.7%
繼發AIHAAIHA
可繼發於下列疾病:
1、自身免疫性疾病:系統性紅斑狼瘡、類風濕關節炎、硬皮症、潰瘍性結腸炎、重症肌無力、自身免疫性甲狀腺炎、低丙種球蛋白血症、異常球蛋白血症、惡性貧血、免疫相關性純紅細胞再生障礙、自身免疫性肝病等。
2、腫瘤性疾病:淋巴瘤、白血病、漿細胞病、組織細胞增生症、某些實體瘤等。
3、感染:各種病毒感染、支原體肺炎、結核、亞急性細菌性心內膜炎、梅毒等。
臨床表現
溫抗體型
 自身免疫溶血性貧血
自身免疫溶血性貧血一般起病緩慢,表現為乏力、頭暈、黃疸等症。病情較重者,貧血發展快, 面色蒼白,伴有氣急、暈倒、全身衰竭或循環衰竭症狀,甚至神誌異常,同時尿色加深及皮膚鞏膜黃染較重。在病毒或細菌感染後病情可突然加重,黃疸、貧血嚴重,並見發熱、頭暈、腹痛、腰背酸痛、食欲不振、嘔吐甚至衰竭狀態。半數以上脾大,1/3肝大。繼發性者伴有淋巴瘤、系統性紅斑狼瘡、類風濕性關節炎等原發病的表現。
冷抗體型
免疫性溶血性貧血:包括冷凝集病(CAS,亦稱冷凝集素病,冷凝集素綜合徵)與陣發性冷性血紅蛋白尿兩類。冷凝集病表現為在寒冷的環境中指端、足尖、鼻尖、耳郭等皮膚暴露處紫紺、冰冷,自覺局部麻木、微痛,加溫後症狀消失。陣發性冷性血紅蛋白尿(PCH)表現為遇冷後再回到溫暖的環境中幾分鐘至幾小時內突然出現腰腿酸痛,腹痛,寒戰高熱,頭痛,噁心嘔吐,隨後排出醬油色尿但多持續時間短,偶有幾大者,可伴有黃疸和脾大。本病罕見。
冷凝集素綜合徵
多見於中老年人,在寒冷環境中,大多數患者表現有耳郭、鼻尖、手指及足趾發紺,復溫後消失。主要症狀為貧血和黃疸。肝、脾、淋巴結一般不大。
實驗室檢查
溫抗體型
 自身免疫溶血性貧血
自身免疫溶血性貧血1、血常規
一般就診時血紅蛋白已有中重度減低,MCV多正常或輕度增高。網織紅細胞增高,但溶血緩慢或件惡性病、感染的病例可不增高。溶血危象時網織紅細胞極度減少。血片中可有紅細胞形態的改變,如多量的球形紅細胞及數量不等的幼紅細胞及少量線粒幼細胞。
2、血清膽紅素
增高,可達42.8~85.5umol/L。
3、尿常規
溶血嚴重者尿中可出現血紅蛋白尿或/及含鐵血黃素顆粒。尿膽原增多。
4、骨髓象
紅細胞系顯著增生,但因感染或惡性病等繼發性病例紅細胞系可以不增多,甚至減少。溶血危象時骨髓象呈再生障礙表現,有時可見類巨幼紅細胞改變⑤抗人球蛋白試驗(Coomb'S試驗):直接試驗大多呈陽性,主要為IgG和C3型。約2/3患者間接試驗陽性。約2%~4%病人Coomb'S試驗呈陰性。
冷凝集病
1、血常規:血紅蛋白輕至中度降低,網織紅細胞可輕度增高。
2、膽紅素:可增高。
3、尿:溶血反覆發作者可有含鐵血黃素尿。
4、冷凝素試驗:陽性。4℃效價可高達1:1000甚至1:16000,30℃時,在白蛋白或生理鹽水內,若凝集素效價仍較高,有診斷意義。
5、抗人球蛋白試驗;直接試驗陽性,為C3型。
陣發性冷性血紅蛋白尿
1、血象
頻繁發作溶血的病例可有血紅蛋白的明顯下降,血漿中結合珠蛋白消失,血紅素減少,出現高鐵血紅蛋白和游離血紅蛋白。
2、尿常規:反覆發作者有含鐵血黃素尿。
3、冷熱溶血試驗:陽性。
4、抗進球蛋白試驗:陽性,為C3型。
診斷標準
根據有溶血的臨床表現,抗人球蛋白試驗陽性,即可作出診斷。診斷成立後,還應進一步確定是原發性或繼發性。對此,可結合臨床表現進行考慮。
在有些繼發性AIHA患者,其原發病常在出現溶血性貧血之後才出現,因此,長期追蹤觀察,可及時發現原發病。此外,血清學檢查結果也可能有助於原發性與繼發性AIHA的鑑別。一般而論,IgG型多見於慢性原發性患者,而IgM 型與補體型多見於繼發性患者。
對於抗人球蛋白試驗陰性的可疑病例,其診斷依據主要依靠臨床表現和腎上腺糖皮質激素的治療反應來判斷。如用腎上腺糖皮質激素後有效,結合臨床上亦可考慮本病。
冷凝集素病和PCH的診斷,除根據臨床表現和抗人球蛋白試驗外,前者冷凝集素試驗陽性,後者冷熱溶血試驗陽性,均具有確診意義。
鑑別診斷
 自身免疫溶血性貧血
自身免疫溶血性貧血1、抗體型自身免疫性溶血性貧血與球形紅細胞增多症的鑑別:
溫抗體型自身免疫性溶血性貧血部分病例外周血球形紅細胞增多,但球形紅細胞增多症除球形紅細胞增多外,還有家族遺傳傾向,Coomb'S試驗陰性等特徵。
2、冷凝集素病(CAS)與雷諾病(Reynaud病)的鑑別:
兩者均有手足紫紺,但雷諾病紫紺的出現不一定在寒冷季節,且多為對稱性,鼻尖和耳輪並不發生紫紺,冷凝集素試驗和Coomb'S試驗均陰性。
3、陣發性冷性血紅蛋白尿(PCH)
(1)與陣發性睡眠性血紅蛋白尿(PNH)的鑑別:陣發性冷性血紅蛋白尿是在遇冷後急性發作的溶血性疾病,血紅蛋白尿一般持續幾小時,Hams試驗、糖水試驗、蛇毒因子、Rous試驗均陰性。
(2)與冷凝集素病的鑑別:兩者發作均與寒冷有關,同屬寒冷性免疫性溶血性貧血。但冷凝集素病症狀以耳郭、鼻尖、手指發紺為主,可有貧血與黃疸,冷凝集素試驗陽性;陣發性冷性血紅蛋白尿則表現為寒戰高熱,乏力,腰背痛,隨後出現血紅蛋白尿,冷熱溶血試驗陽性。
(3)與行軍性血紅蛋白尿的鑑別:兩者均有血紅蛋白尿,但陣發性冷性血紅蛋白尿是在寒冷情況下發生,行軍性血紅蛋白尿發生前常有長途行車或跑步史,突然排出紅褐色尿,6-12h後,尿色基本正常。
治療原則
治本
尋找並消除病因自身免疫性溶血性貧血治療。
激素
自身免疫溶血性貧血
自身免疫溶血性貧血腎上腺皮質激素和其他免疫抑制劑主要適應於治療免疫性溶血性貧血,如自體免疫性溶貧、陣發性睡眠性血紅蛋白尿等,可用潑尼松40毫克/天,分次口服,或用氫化可的松靜脈滴注;無效時可加量或加用環磷醯胺、硫唑嘌呤等口服。
潑尼松一般在1周內發揮作用,緩解後逐漸減量維持,維持量每天不應少於15-20毫克,一般連續套用8-12周后可逐漸停用。
脾切除
適應於自身免疫性溶血性貧血治療:①遺傳性球形紅細胞增多症;②溶血嚴重或脾顯著腫大的球蛋白生成障礙性貧血(地中海貧血);③自體免疫性溶貧激素治療無效,丙酮酸激酶缺乏等溶血性貧血。臨床實踐中一般脾切除的適應證為:
A、皮質激素治療無效或有禁忌證者;
B、需大劑量皮質激素維持者;
C、溶血常復發者;
D、皮質激素加免疫抑制劑治療無效者。
中醫治療
本病治療以扶正祛邪為原則,根據不同的發病機制分別採用清熱利濕、益氣養血,益氣養血兼清濕熱,補益氣血、活血祛瘀,溫腎助陽、祛寒除濕的治療方法。
預防調理
預防
自身免疫溶血性貧血
自身免疫溶血性貧血1、冷凝集素病、冷性血紅蛋白尿患者應避免受涼,通常的裸露部位也不應忽視。
2、溫抗體型AIHA溶血的發作無明顯誘因,部分患者的發作與外傷、手術、妊娠、精神刺激有關,應盡力避免。
3、對患者解釋本病的基本概念、防治要點,說明預防的重要性及實施方法。
4、鼓勵患者在藥物充分治療條件下自我鍛鍊與調養,以提高體質。
調理
1、生活調理:感染、勞累、精神刺激等常常成為該病發生急性溶血的誘因,生活調理至關重要,要起居有常隨氣候的變化及時的增減衣服,避免外感。
2、飲食調理:本病病機為虛夾雜,病及多為氣血兩虧,腎則脾腎俱虛,平素以虛為主或虛中夾實。禁忌生冷瓜果以免損傷脾胃,辛辣滋補之品亦當避免或少食,時時顧護脾胃。
3、精神調理:正確對待疾病、避免重體力勞動。避免精神緊張、調情致,勿激動,可適當鍛鍊,以增強體質,但氣血虧虛者勿練氣功,以免動氣耗血,加重氣血虛。
病例
鹽城4歲女童患病渾身變綠
 患病女童全身變綠
患病女童全身變綠2012年10月,江蘇鹽城急性白血病患者語桐進行造血幹細胞移植後出現排異現象。2013年5月,4歲的語桐被確診患上自身免疫性溶血性貧血,由於體內膽紅素不斷累積、過高,導致全身皮膚變綠。專家稱,這種病例非常罕見,全球見諸報導的病例,至今大概也只有兩三例。

